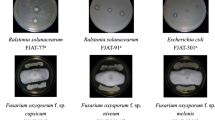

Abstract
Plants have their own defense mechanisms such as induced systemic resistance (ISR) and systemic-acquired resistance. Bacillus spp. are familiar biocontrol agents that trigger ISR against various phytopathogens by eliciting various metabolites and producing defense enzyme in the host plant. In this study, B. paralicheniformis (strain EAL) was isolated from the medicinal plant Enicostema axillare. Butanol extract of B. paralicheniformis showed potential antagonism against Fusarium oxysporum compared to control well (sterile distilled water) A liquid chromatography mass spectrometry analysis showed 80 different compounds. Among the 80 compounds, we selected citrulline, carnitine, and indole-3-ethanol based on mass-to-charge ratio, database difference, and resolution of mass spectrum. The synthetic form of the above compounds showed biocontrol activity against F. oxysporum under in vitro condition in combination, not as individual compounds. However, the PCR amplification of 11 antimicrobial peptide genes showed that none of the genes amplified in the strain. B. paralicheniformis inoculation challenged with F. oxysporum on tomato plants enhanced production of defense enzymes such as peroxidase (POD), superoxide dismutase (SOD), phenylalanine ammonia lyase (PAL), polyphenol oxidase (PPO), and proline compared to control plants (without inoculation of B. paralicheniformis) at significant level (p < 0.005). Stem of tomato plants expressed higher POD (2.2-fold), SOD (2.2-fold), PPO (1.9-fold), and PAL (1.3-fold) contents followed by the leaf and root. Elevated proline accumulation was observed in the leaf (1.8-fold) of tomato plants. Thus, results clearly showed potentiality of B. paralicheniformis (EAL) in activation of antioxidant defense enzyme against F. oxysporum-infected tomato plants and prevention of oxidative damage though hydroxyl radicals scavenging activities that suppress the occurrence of wilt diseases.
Similar content being viewed by others
Avoid common mistakes on your manuscript.
Introduction
Bacillus species are prominent biocontrol weapons against various phytopathogens. They are proved to be eminent antagonistic because of their ability to replicate rapidly, their resistance against adverse environment, and their broad spectrum of biocontrol potential. In addition, a biocontrol study of Bacillus showed them as an efficient plant growth promoter and a systemic resistance inducer (Shafi et al. 2017). Recent research is paying more attention on the production of volatile and nonvolatile secondary metabolites by antagonistic microbes for inhibiting plant pathogens (Chuankun et al. 2004). Research on Bacillus reported that there are several secondary metabolites involved in the inhibition of various plant pathogens. It has been identified that volatile organic compound (VOC) of B. amyloliquefaciensis is a potential antagonist to Fusarium oxysporum f. sp. cubense (Yuan et al. 2012). Secondary metabolites extracted from Bacillus subtilis shown to have biocontrol potential against pathogenic fungi have been reported earlier (Dunlap et al. 2019). However, compare to volatile secondary metabolites, nonvolatile metabolites are least studied. Hence, this research focuses on the antagonistic potential of nonvolatile metabolites.
Induced systemic resistance (ISR) is enhancement of system-acquired resistance (SAR) in plant defense mechanism by antagonistic microbes, to protect plants against several bacterial and fungal phytopathogens (Shafi et al. 2017; Van Loon 2007; Choudhary and Johri 2009). Studies have reported that enhancement in the system resistance increases the production of antioxidant enzyme in the host against pathogenic microbes (Lavanian et al. 2006). Recognition of pathogen by host plant induces hypersensitive response which leads to production of reactive oxygen species (ROS). Higher production of ROS enhances oxidative stress in host plant and stimulates plant defense responses (Samsatly et al. 2018). Yasmin et al. (2016) reported that inhibition of plant diseases is correlated with enhanced production of antioxidant enzymes such as peroxidase (POD), phenylalanine ammonialyase (PAL), and polyphenol oxidase (PPO) in the host plant. The production of reactive oxygen species by plant–pathogenic interaction is regulated by different antioxidant enzymes (Liu et al. 2011; Ponce de Leon and Montesano 2013; Bolouri Moghaddam et al. 2016). Studies have reported that rhizosphere Bacillus sp. enhances plant defense mechanisms (Pieterse et al. 2014; Solanki et al. 2012). A study reported that B.subtilis induced production of antioxidant enzymes in plants infected with Erwinia carotovora subsp. Carotovora (Chandrasekaran and Chun 2016). Another study showed that antagonists Pseudomonas aeruginosa, Trichoderma, and B. subtilis could induce production of defense enzyme in combination with each other (Jain et al. 2012).
Fusarium oxysporum is a soil-born fungal pathogen that causes wilt diseases in solanaceous crops and is difficult to control. Instead of chemical methods, biological methods are more reliable. In recent times, biological control agents and their secondary metabolites challenging F. oxysporum are highly explored. However, the role of Bacillus strain or their nonvolatile secondary metabolites in maintaining host defense is least studied and needs to be explored more. Hence, in this study, nonvolatile compounds of B. paralicheniformis were characterized and their role in induction of defense enzyme in tomato plants challenging F. oxysporum was studied in detail.
Materials and methods
Culture condition
An antagonistic strain of B. paralicheniformis (strain EAL) was isolated from the leaf of medicinal plant Enicostema axillare, for isolation leaf samples were surface sterilized and homogenized using ionized water. Bacteria were isolated on nutrient agar plates followed by standard serial dilution techniques. Plates were incubated at room temperature for 24 h. Purified isolates were preserved as a 20% of glycerol stock. Isolated bacteria were identified based on biochemical and 16S rDNA sequencing. Pathogenic strain of F.oxysporum was obtained from Indian Type Culture Collection (ITCC). Bacterial and fungal cultures were maintained in the glycerol stock and potato dextrose agar slant, respectively. The antagonistic activity of B. paralicheniformis against F. oxysporum was determined by dual-plate assay (Dennis and Webster 1971).
Extraction of antimicrobial compounds
Bacillus paralicheniformis strain was cultivated in a 50 ml nutrient broth contained in an Erlenmeyer flask and incubated for 72 h at 37 °C on an orbital shaker. After incubation, the culture was centrifuged at 5000 g for 5 min and the supernatant was separated. The collected supernatant was mixed with different organic solvents such as acetone, butanol, chloroform, ethyl acetate, and methanol at a ratio of 1:1. The mixture was kept on a rotator vacuum evaporator to obtain dry secondary metabolites (Bhardwaj et al. 2015). The crude extracts were dissolved in ionized distilled water (1 mg/ml) concentration and stored at 4 °C. The extracted secondary metabolites were studied for their antimicrobial activity against wilt pathogen F.oxysporum by dual-plate technique (Tagg and McGiven 1971) and inhibition of mycelia growth was observed.
Identification of secondary metabolites
The secondary metabolites produced by B. paralicheniformis were identified by liquid chromatography–mass spectrometry (LC–MS) analysis at IIT Bombay, SAIF Centre, using TOF/QTOF, version BS125, mass spectrometer equipped with an electrospray source operated in positive mode (+ ESI). The mobile phase was water with 0.1% formic acid (FA), and mobile phase B was 10% water with 90% acetonitrile and 0.1% FA. Thereafter, 3 µl sample was injected into the LC column. Peptides were eluted directly off the column into the Q-TOF system using a gradient of 5–95% mobile phase B over 30 min at a flow rate of 0.2 ml/min. Total run time of the LC was 30 min. The formation of chromatogram was identified using a detector and the components were analysed based on mass per charge (m/z) ratio.
Biocontrol activity of synthetic form of secondary metabolites
Secondary metabolites identified by the LC–MS analysis were further checked for their biocontrol activity against F. oxysporum. The selected forms of the synthetic secondary metabolites such as citrulline, carnitine, and indole-3-ethanol were procured from HiMedia (Mumbai, India). The compounds were dissolved in sterile distilled water and checked against F. oxysporum at 1 mg/ml concentration by dual-plate method.
Identification of antimicrobial peptide genes
Identification of antimicrobial peptide (AMP) genes present in the strain B. paralicheniformis (EAL) was performed using PCR assay with different primers such as fengycin, iturin, surfactin, bacillomycin, subtilin, and subtilosin (Ramarathnam et al. 2007; Chung et al. 2008). The PCR cycle conditions for given AMP genes includes: 95 °C for 5 min, 35 cycle of 95 °C for 1 min, annealing temperature (46–60 °C) for 1 min and 72 °C extension for 1.5 min and final extension at 72 °C for 7 min (Table S1).
In vivo experiment
In vivo experiment was conducted in triplicate and pots were arranged in a completly randomized factorial design with following treatment: T1 (tomato seeds treated with B. paralicheniformis) and control (untreated tomato seeds). Tomato seeds were washed with tap water followed by subsequent wash with 2% sodium hypochloride for 2 min and 70% of ethanol for 2 min followed by washing with ionized distilled water three times. The seeds were soaked with the pure culture of B. paralicheniformis (108 CFU/ml) for 1 h and were allowed to dry on sterile filter paper. The seeds were immediately sowed in pots filled with sterile loam soil under greenhouse conditions (30–32 °C, RH ~ 58%, 12 h/12 h photoperiod). After 4 weeks of growth, the roots of both treated and control plants tomato seedlings were inoculated with conidial mass of F. oxysporum (104 conodia per ml). The pots were regularly irrigated to maintain moisture condition. After 1 month of pathogen inoculation, the tomato plants were harvested and their growth was observed in terms of length, wet weight, and dry weight of root and shoot and compared to control. Apart from plant attributes, increase in antioxidant enzyme was also determined and compared to control.
Extraction of crude enzymes for ISR determinants
The tomato plants inoculated with F. oxysporum and treated with B. paralicheniformis were harvested for determination of defense-related enzymes such as POD, superoxide dismutase (SOD), PPO, and PAL.
For determination of POD, PPO, and SOD, 0.5 g plant samples such as root, shoot, and leaf was collected and macerated with 50 mM sodium phosphate buffer (pH 6.0) using a pre-chilled mortar and a pestle. The homogenate was centrifuged at 5000 g at 4 °C for 10 min and the supernatant was collected as a crude enzyme extract (Anand et al. 2007). Each analysis was performed in triplicates.
Estimation of POD
For estimation of POD (EC 1.11.1.7), 100 µl homogenate was mixed with 3 ml buffer solution (50 mM; pH 6.0) and 50 µl guaiacol solutions (20 mM). The reaction was initiated by addition of 30 µl H2O2 (12.3 mM) solution. Reaction mixture without enzyme was prepared as control. The absorbance was measured at 420 nm after 30 s interval for 3 min. The enzyme activity was expressed as unit per g FW min−1 (Xie et al. 2017).
Estimation of PPO
PPO (EC 1.14.18.1) was estimated as per the procedure described by Jain et al. (2012) with little modification. The reaction mixture contained 0.1 ml homogenate and 3.0 ml substrate solution (0.1 M pyrogallol + 0.1 M sodium phosphate buffer; pH 7.4). Blank was added only with the substrate. Increase in absorption was measured at 420 nm at 25 °C for 5 min. PPO activity was calculated as per g−1 FW min−1.
Estimation of SOD
The activity of SOD was assayed, as described by Gay and Tuzun (2000), to measure the capacity of the crude enzyme to inhibit photochemical reduction of NBT (nitroblue tetrazolium chloride). For this, 1 ml homogenate was added in a reaction mixture containing 0.6 ml sodium phosphate buffer (50 mM; pH 7.8), 0.39 ml methionine (100 mM), 0.0006 ml riboflavin (10 mM), 0.06 ml EDTA (5 mM), and 0.3 ml NBT (750 µM). The final volume of 3 ml was achieved by addition of distilled water. The reaction mixture without enzyme served as a blank, and NBT was used as a blank to calibrate the spectrophotometer. The tubes were illuminated with a 200 W bulb for 30 min. Absorbance was taken at 520 nm. Amount of enzyme required to cause 50% inhibition between NBT and riboflavin compared to control was defined as unit of SOD activity.
Estimation of PAL
For estimation of PAL activity, tomato plant parts such as leaf, stem, and root were homogenated with 50 mM borate buffer (pH 8.8) containing 5 mM β-mercaptoethanol. The homogenate was centrifuged at 8,000 g for 10 min at 4 °C. The extracted supernatant was used as enzyme extract. The reaction mixture comprising 1.0 ml enzyme extract was mixed with 1.0 ml borate buffer (50 mM; pH 8.8) and 1.0 ml l-phenylalanine (20 mM). The mixture was incubated at 37 °C for 60 min. After 60 min, the reaction was terminated by addition of 0.1 ml HCL (6.0 M). The amount of trans-cinnamic acid (TCA) was measured at 290 nm and the enzyme activity was expressed in terms of µmol TCA/g FW.
Estimation of proline
Proline content of tomato plants was estimated as per the procedure described by Jain et al. (2012). The extract was prepared by homogenizing the root, shoot, and leaf of tomato plant with 3% sulfosalicylic acid and centrifuged at 8,000 g at 4 °C for 10 min. Thereafter, 2 ml supernatant was mixed with 2 ml glacial acetic acid and 2 ml ninhydrin (1.25 g ninhydrin warmed in 30 ml glacial acetic acid and 20 ml in 6 mol l−1 phosphoric acid until resolved. The mixture was kept in a boiling water bath for 1 h. The reaction was terminated by keeping the tubes in an ice bath. Toluene was added in 1:2 ratio in the reaction mixture and vortexed for 15–20 s. The absorbance of the top purple aqueous layer was recorded at 520 nm in the spectrophotometer. The concentration of proline was determined according to the standard curve plotted with known concentrations of L-proline.
Statistical analysis
The software used for statistical analysis was SPSS, 16.0 (SPSS Inc., Chicago, IL). Data were represented in terms of mean ± standard deviation of at least three replication of each test. Data were statistically analyzed by analysis of variance. The treatment mean values were compared by Duncan’s multiple range tests at 95% significance level.
Results
Isolation and identification of B. paralicheniformis
A total of 14 isolates were recovered from the roots, stems, and leaves of E. axillare medicinal plant. The dual culture activity of these isolates against F. oxysporum showed that the isolate EAL possessed potential inhibition activity. The isolate EAL was identified as B. paralicheniformis by 16S rDNA sequence analysis with 98% of similarity with NCBI, GenBank database (MN71578). The strain EAL (B. paralicheniformis) was used for further experiments.
Identification of secondary metabolites and antimicrobial peptide genes
The extraction of crude secondary metabolites from B. paralicheniformis showed inhibition of mycelial growth of F. oxysporum with butanol extract (Fig. 1). However, the crude extract from acetone, ethylacetate, chloroform, and methanol did not show any remarkable inhibition activity against F. oxysporum. The butanol crude extract was further analyzed by LC–MS. The LC–MS analysis depicted several secondary metabolites with different retention times. The identified components were shortlisted manually on the basis of their functional importance demonstrated in literature such as stress tolerance and defense mechanism in plant, database difference value ± 5 ppm, mass per charge ratio (m/z), and MS/MS ionization pattern [M + H]+ (Shimizu et al. 2018). Compounds such as citrulline, carnitine, and indole-3-ethanol were identified as the potential components that may be responsible for inhibition of F. oxysporum. In the case of citrulline (m/z 158.09), mass fragmented into 158.09 and 159.0938, confirming the compound to be citrulline (Fig. 2b). Likewise, the fragmented mass of carnitine (m/z 144.10) such as 144.10, 145.10, and 146.10 with [M + H]+ ionization was enough evidence to identify carnitine (Fig. 2c). Mass fragment (144.07, 145.08, and 146.08) of indole-3-ethanol (m/z 144.07) confirmed the presence of indole-3-ethanol (Fig. 2d; Table 1).
Biocontrol analysis of the synthetic compounds such as citrulline, carnitine, and indole-3 ethanol revealed that individual compounds did not show any activity against F. oxysporum. However, the combination of all three compounds or in combination of any two compounds in equal concentration showed potential antifungal activity against F. oxysporum (Fig. 3). It is interesting to note that the biocontrol activity may be due to combination of many compounds present in B. paralicheniformis. Amplification of AMP genes using 11 primers showed none of the AMP genes were amplified in the strain B. paralicheniformis (EAL). The results suggest that AMP genes are not the only mechanisms involved in pathogen inhibition and other compounds or unexplored properties may be involved. This is the first report suggesting that combinations of citrulline, carnitine, and indole-3 ethanol are involved in mycelial inhibition of F. oxysporum.
In vivo experiment
In the in vivo pot experiment, inoculation of B. paralicheniformis (EAL) enhanced biocontrol index (BI) up to 60.78% and reduced diseases incidence (DI) by 33.33% compared to control plants (BI 5.55%; DI 85.0%) (Fig. 4a). Apart from BI and DI, the inoculated seedling also showed a significant (p < 0.05) increase in plant growth parameters (Table 2) compared to control (Fig. 4b).
Occurrence of diseases incidence (DI) and biocontrol index (BI) in control and treated tomato plants. a DI and BI of tomato plants inoculated with B. paralicheniformis (EAL) compared to control. Data were analyzed with one way ANOVA analysis of variance and treatment mean were compared. Verticals bars were indicated standard error standard error (± SE) of mean deviation. b Inoculation of B. paralicheniformis enhanced tomato plant growth compared to control plants
Identification of defense-related enzymes
Induced systemic resistance activities such as POD, SOD, PPO, and PAL of F. oxysporum inoculated with B. paralicheniformis showed enhanced potential compared to the control plant. Induction of POD activity was higher in stems (5.3-fold) compared to roots (2.2-fold) and leaves (2.7-fold) of the treated as well as control plants (Fig. 5). The same pattern of increased activity was also observed in SOD (15.5-, 8.5-, and 2.12-fold), PPO (2.3-, 1.9-, and 1.8-fold), and PAL (1.3-, 1.3-, and 1.2-fold) analyses (Fig. 5a, 5b, 5c, 5d).
Enhancement of antioxidant enzyme production in F. oxysporum infected tomato plants by inoculation of B. paralicheniformis compared to control plants. a Production of POD enzyme. b Production of SOD enzyme. c Production of PPO enzyme. d Production of PAL enzyme. e Production of amino acid proline. Data were analyzed using one way ANOVA analysis of variance compared to treatment mean Vertical bar indicted ± SE standard error
Estimation of proline
Estimation of proline showed higher proline production in leaf followed by stem and root of treated as well as control plants. In contrast to control, B. paralicheniformis–inoculated plant induced 1.8-fold increase proline in leaves as well as stems, whereas in root 4.8-fold proline increase was observed (Fig. 5e).
Discussion
Biocontrol efficiency, plant growth promotion, and increased uptake of nutrients by various Bacillus spp have been reported by many researchers (Zalila-Kolsi et al. 2016; Elanchezhiyan et al. 2018). Considering this, the present study was carried out on the medicinal plant E. axillare–associated B. paralicheniformis for assessing its potential antagonist activity against F. oxysporum. Earlier research showed that beneficial microbes are involved in the management of plant health with various criteria that include production of secondary metabolites, VOCs, enzymes, and growth hormone (Rahid and Chung 2017). Therefore, secondary metabolites were extracted and studied for their antimicrobial potential. Out of five extractions, butanol extract was the most potent; the secondary metabolites were identified by LC–MS analysis. Metabolites such as citrulline, carnitine, and indole-3-ethanol were identified as potential ones among all the reported metabolites. These metabolites play a diverse role in plant defense. It has been reported that citrulline found in watermelon leaves is related to drought tolerance capacity and efficient hydroxyl radical scavenging activity (Akashi et al. 2001). Whereas carnitine enhances the tolerance capacity of an organism towards salt stress ((Oney-Birol et al. 2019), indole-3-ethanol stimulates the plant growth and modifies plant defense mechanisms (Mukherjee et al. 2013).
The result of the present study is also in agreement with previous studies that compounds such as flavonoids, lignin, and other secondary metabolites can defend plants against a wide range of phytopathogens (Campos et al. 2014; Mejía et al. 2014). Under in vivo condition, B. paralicheniformis–inoculated tomato plants showed enhanced root, shoot, and leaf biomass along with enhanced level of BI and reduced DI compared to control. Khan et al. (2018) reported that tomato plants inoculated with B. subtilis had shown plant growth promotion activity as well as antifungal activity against F. oxysporum. Apart from BI and DI, B. paralicheniformis inoculation enhanced the induction of antioxidant enzymes such as PPO, POD, SOD, and PAL in response to F. oxysporum compared to control plants. Previous studies reported that plant POD provides first line of defense mechanism to plants against pathogens (Ighodaro et al. 2017). POD has higher affinity to H2O2-induced oxidative stress and is involved in its removal (Wang et al. 2012). Hence, higher production of H2O2 in tomato plants due to F. oxysporum infection leads to a corresponding enhanced production of antioxidant POD. Li and Steffens (2002) reported that increased PPO activity enhances disease resistance in host plants. In the present study, an increased expression of PPO in the stem and leaf was observed whereas the root system evoked very less amount of PPO. A previous work reported that PPO could not polarize in the root system and accumulates in higher amount in the stem and leaf (Anthony et al. 2017). SOD constitutes the first-line defense against ROS under stress conditions (Alscher et al. 2002; Ighodaro et al. 2017). It is also involved in O2 removal. Hence, increased oxidative stress induces production of SOD enzyme in the host plant. This study reported significantly increased level of SOD production in the B. paralicheniformis–inoculated plant infected with F. oxysporum. Higher PAL activity was observed in B. paralicheniformis–inoculated plants than unchallenged control plants. PAL activity was significantly higher in the leaf than stem, and the result is in line with that of a previous study reporting high PAL production in patchouli leaves inoculated with R. solanacearum compared to stem and root (Xie et al. 2017). In addition, a study showed that PAL is involved in the production of phenol, which leads to defense functions in plants such as reinforcement of plant cell wall, antimicrobial activity, and synthesis of signaling compounds like salicylic acid (Wen et al. 2005). It has been identified that treatment of plants with biocontrol agents also causes a significant increase in phenolic contents, and higher level of phenolic content makes host plants resistant against pathogen (Shoresh and Harman 2008; Abo-Elyousr et al. 2009). Hence, induction of PAL produces phenolic components in the infected plants, which provides the first line of defense mechanisms that challenge respective pathogens. Proline is a well-known protein or secondary metabolite that is involved in the stress resistance mechanisms such as osmoprotection, drough and salinity stress tolerance in plants (Chun et al. 2018). Besides, proline enhances production of reactive oxygen species and hypersensitive response, which shows induction of plant defense mechanism (Liang et al. 2013).
In this study, the leaves of treated plants showed higher proline accumulation followed by stems and roots. A study reported that Arabidopsis thaliana inoculated with Pseudomonas syringae showed more amount of proline accumulation in leaf tissue (Fabro et al. 2004). The present study results are consistent with previous findings that pathogen-infected plants inoculated with beneficial microbes may modify plant metabolic process in response to specific stimuli (Van der Ent et al. 2009). In conclusion, the present study showed that B. paralicheniformis has antimicrobial potential against wilt-causing F. oxysporum. The LC–MS study provided details of secondary metabolites in the crude extract of B. paralicheniformis. Their role in plant benefits gives partial confirmation that the identified metabolites may be responsible for suppression of wilt infection. Apart from controlling the F. oxysporum in vitro and in vivo, B. paralicheniformis also stimulated the ISR and enhanced antioxidant enzyme in tomato plants. Hence, it is concluded that medicinal plant–associated Bacillus spp are a powerful tool for the management of wilt pathogen F. oxysporum.
References
Abo-Elyousr KA, Hashem AEH, Ali EH (2009) Integrated control of cotton root rot disease by mixing fungal biocontrol agents and resistance inducers. Crop Prot 28:295–301
Akashi K, Miyake C, Yokota A (2001) Citrulline, a novel compatible solute in drought-tolerant wild watermelon leaves, is an efficient hydroxyl radical scavenger. FEBS Lett 508:438–442
Alscher RG, Erturk N, Heath LS (2002) Role of superoxide dismutases (SODs) in controlling oxidative stress in plants. J Exp Bot 53:1331–1341
Anand T, Chandrasekaran A, Kuttalam S, Raguchander T, Prakasam V, Samiyappan R (2007) Association of some plant defense enzyme activities with systemic resistance to early leaf blight and leaf spot induced in tomato plants by azoxystrobin and Pseudomonas fluorescens. J Plant Interact 2:233–244
Anthony KK, George DS, Baldev Singh HK, Fung SM, Santhirasegaram V, Razal Z, Somasundram C (2017) Reactive oxygen species activity and antioxidant properties of Fusarium infected bananas. J Phytopath 165:213–222
Bhardwaj A, Sharma D, Jodan N, Agrawal PK (2015) Antimicrobial and phytochemical screening of endophytic fungi isolated from spikes of Pinus roxburghii. Arch Clin Microbiol 6:1–9
Bolouri Moghaddam MR, Vilcinskas A, Rahnamaeia M (2016) Cooperative interaction of antimicrobial peptides with the interrelated immune pathways in plants. Mol Plant Pathol 17:464–471
Campos ML, Kang JH, Howe GA (2014) Jasmonate-triggered plant immunity. J Chem Ecol 40:657–675
Chandrasekaran M, Chun SC (2016) Expression of PR-protein genes and induction of defense-related enzymes by Bacillus subtilis CBR05 in tomato (Solanum lycopersicum) plants challenged with Erwinia carotovora subsp. carotovora. Biosci Biotechnol Biochem 80:2277–2283
Choudhary DK, Johri BN (2009) Interactions of Bacillus spp. and plants-with special reference to induced systemic resistance (ISR). Microbiol Res 164:493–513
Chuankun X, Minghe M, Leming Z, Keqin Z (2004) Soil volatile fungistasis and volatile fungistatic compounds. Soil Biol Biochem 369:997–2004
Chun SC, Paramasivan M, Chandrasekaran M (2018) Proline accumulation influenced by osmotic stress in arbuscular mycorrhizal symbiotic plants. Front Microbiol 9:2525
Chung S, Kong H, Buyer JS, Lakshman DK (2008) Isolation and partial characterization of Bacillus subtilis ME488 for suppression of soil borne pathogens of cucumber and pepper. Appl Microbiol Biotechnol 80:115–123
Dennis C, Webster J (1971) Antagonistic properties of species-groups of Trichoderma: II. Production of volatile antibiotics. Trans Br Mycol Soc 57:41–44
Dunlap CA, Bowman MJ, Rooney AP (2019) Iturinic lipopeptide diversity in the Bacillus subtilis species group-important antifungals for plant disease biocontrol applications. Front Microbiol 10:1794
Elanchezhiyan K, Keerthana U, Nagendran K, Prabhukarthikeyan SR (2018) Multifaceted benefits of Bacillus amyloliquefaciens strain FBZ24 in the management of wilt disease in tomato caused by Fusarium oxysporum f. sp. lycopersici. Physiol Mol Plant Pathol 103:92–101
Fabro G, Kovacs I, Pavet V, Szabados L (2004) Proline accumulation and AtP5CS2 gene activation are induced plant pathogen incompatible interactions in Arabidospis. Mol Plant Microbe Interact 17:343–350
Gay PA, Tuzun S (2000) Temporal and spatial assessment of defense responses in resistant and susceptible cabbage varieties during infection with Xanthomonas campestris pv. campestris. Physiol Mol Plant Path 57:201–210
Jain A, Singh S, Kumar Sarma B, Bahadur Singh H (2012) Microbial consortium–mediated reprogramming of defence network in pea to enhance tolerance against Sclerotinia sclerotiorum. J Appl Microbiol 112:537–550
Kets EPW, Galinski EA, de Bont JAM (1994) Carnitine: a novel compatible solute in Lactobacillus plantarum. Arch Microbiol 162:243–248
Khan N, Martínez-Hidalgo P, Ice TA, Maymon M, Humm EA, Nejat N, Sanders ER, Kaplan D, Hirsch AM (2018) Antifungal activity of Bacillus species against Fusarium and analysis of the potential mechanisms used in biocontrol. Front Microbiol 9:2363
Lavania M, Chauhan PS, Chauhan S, Singh HB (2006) Induction of plant defense enzymes and phenolics by treatment with plant growth-promoting rhizobacteria Serratia marcescens NBRI1213. Curr Microbiol 52:363
Leon IP, Montesano M (2013) Activation of defense mechanisms against pathogen in mosses and flowering plants. Int J Mol Sci 14:3178–3200
Li L, Steffens JC (2002) Over expression of polyphenol oxidase in transgenic tomato plants results in enhanced bacterial disease resistance. Planta 215:239–247
Liang X, Zhang L, Natarajan SK, Becker DF (2013) Proline mechanisms of stress survival. Antioxid Redox Signal 19:998–1011
Liu TT, Wu P, Wang LH, Zhou Q (2011) Response of soybean seed germination to cadmium and acid rain. Biol Trace Elem Res 144:1186–1196
Mejía LC, Herre EA, Sparks JP, Winter K (2014) Pervasive effects of a dominant foliar endophytic fungus on host genetic and phenotypic expression in a tropical tree. Front Microbiol 12:479
Mukherjee PK, Horwitz BA, Singh US, Mukherjee M (2013) Trichoderma: biology and applications. CABI 2013:16
Oney-Birol S (2019) exogenous L-carnitine promotes plant Growth and cell Division by Mitigating Genotoxic Damage of Salt Stress. Sci Rep 9:1–12
Pieterse CMJ, Zamioudis C, Berendsen RL, Weller DM (2014) Induced systemic resistance by beneficial microbes. Ann Rev Phytopathol 52:347–375
Ramarathnam R, Bo S, Chen Y, Fernando WD (2007) Molecular and biochemical detection of fengycin-and bacillomycin D-producing Bacillus spp., antagonistic to fungal pathogens of canola and wheat. Can J Microbiol 53:901–911
Samsatly J, Copley TR, Jabaji SH (2018) Antioxidant genes of plants and fungal pathogens are distinctly regulated during disease development in different Rhizoctonia solani pathosystems. PLoS ONE 13:e0192682
Shafi J, Tian H, Ji M (2017) Bacillus species as versatile weapons for plant pathogens: a review. Biotechnol Biotechnol Equip 31:446–459
Shimizu T, Watanabe M, Fernie AR, Tohge T (2018) Targeted LC-MS analysis for plant secondary metabolites. In Plant Metabolomics Humana Press, New York, NY 171–181
Shoresh M, Harman GE (2008) The molecular basis of shoot responses of maize seedlings to Trichoderma harzianum T22 inoculation of the root: a proteomic approach. Plant Physiol 147:2147–2163
Solanki MK, Robert AS, Singh RK, Kumar S, Pandey AK, Srivastava AK, Arora DK (2012) Characterization of mycolytic enzymes of Bacillus strains and their bio-protection role against Rhizoctonia solani in tomato. Curr Microbiol 65:330–336
Tagg J, McGiven AR (1971) Assay system for bacteriocins. Appl Microbiol 21:943
van der Ent S, Van Wees SC, Pieterse CM (2009) Jasmonate signaling in plant interactions with resistance-inducing beneficial microbes. Phytochem 70:1581–1588
Van Loon LC (2007) Plant responses to plant growth-promoting rhizobacteria. Eur J Plant Pathol 19:243–254
Wang P, Zhang S, Wang C, Lu J (2012) Effects of Pb on the oxidative stress and antioxidant response in a Pb bioaccumulator plant Vallisneria natans. Ecotoxicol Environ Saf 78:28–34
Wen PF, Chen JY, Kong WF, Pan QH (2005) Salicylic acid induced the expression of phenylalanine ammonia-lyase gene in grape berry. Plant Sci 169:928–934
Xie JH, Chai TT, Xu R, Liu D (2017) Induction of defense-related enzymes in patchouli inoculated with virulent Ralstonia solanacearum. Electron J Biotechnol 27:63–69
Yasmin S, Zaka A, Imran A, Zahid MA, Yousaf S, Rasul G et al (2016) Plant growth promotion and suppression of bacterial leaf blight in rice by inoculated bacteria. PLoS ONE 11:e0160688
Yuan J, Raza W, Shen Q, Huang Q (2012) Antifungal activity of Bacillus amyloliquefaciens NJN-6 volatile compounds against Fusarium oxysporum f. sp. Cubense Appl Environ Microbiol 78:5942–5944
Zalila-Kolsi I, Mahmoud AB, Ali H, Sellami S (2016) Antagonist effects of Bacillus spp. strains against Fusarium graminearum for protection of durum wheat (Triticum turgidum L. subsp. durum). Microbiol Res 192:148–158
Acknowledgements
The authors thank UTU management for providing B. U. Patel research fellowship to carry out this work. Authors also acknowledge IIT Bombay SAIF for providing LC–MS analysis service.
Author information
Authors and Affiliations
Contributions
NA: Designed the work. HNJ: Performed the experiments. KS: Performed AMP gene amplification work. HNJ and NA: Data analysis and drafting the article.
Corresponding author
Ethics declarations
Conflicts of interest
The authors declare that they have no conflict of interest.
Research involving human participants and/or animals
Not applicable.
Informed consent
All the authors read the manuscript and gave their consent for publication.
Additional information
Publisher's Note
Springer Nature remains neutral with regard to jurisdictional claims in published maps and institutional affiliations.
Electronic supplementary material
Below is the link to the electronic supplementary material.
Rights and permissions
About this article
Cite this article
Jinal, H.N., Sakthivel, K. & Amaresan, N. Characterisation of antagonistic Bacillus paralicheniformis (strain EAL) by LC–MS, antimicrobial peptide genes, and ISR determinants. Antonie van Leeuwenhoek 113, 1167–1177 (2020). https://doi.org/10.1007/s10482-020-01423-4
Received:
Accepted:
Published:
Issue Date:
DOI: https://doi.org/10.1007/s10482-020-01423-4